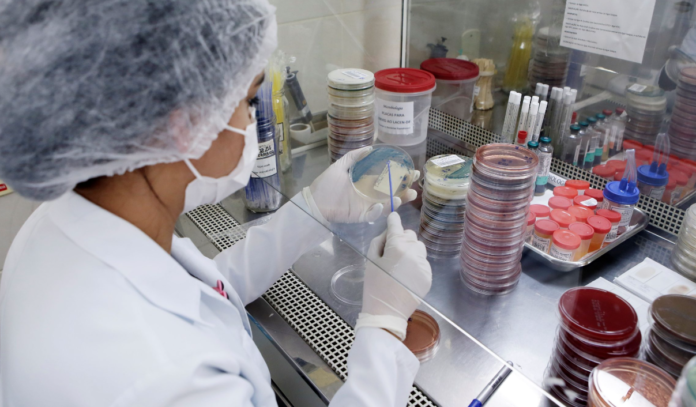

O Laboratório de Microbiologia do Hospital Regional de Santa Maria (HRSM) implementou uma nova técnica de testagem de antibióticos de última geração, o que possibilita dar maior celeridade ao tratamento de pacientes internados com bactérias multirresistentes.
Trata-se da implantação de métodos fenotípicos que contribuem de forma significativa no âmbito laboratorial para auxiliar e orientar a antibioticoterapia mais adequada, tanto quanto econômica, atuando na luta contra a resistência bacteriana. O método começou a ser realizado desde fevereiro. A técnica consiste em identificar mecanismos de resistência com testagem manual, em que é possível descobrir algumas resistências.
Segundo a Organização Mundial da Saúde (OMS), o aumento da resistência bacteriana é considerado um dos grandes problemas em saúde da atualidade. Por isso, a realização do antibiograma é de suma importância para nortear a equipe médica em relação à conduta terapêutica, contribuindo para o uso racional de antibióticos, minimizando falhas e aumentando a sobrevida do paciente, assim como, ajuda a mapear por meio dos fenótipos os perfis predominantes em cada comunidade ou unidade hospitalar.